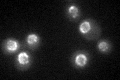
YJR042W
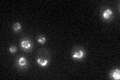
YJR042W

View description
Subunit of the Nup84p subcomplex of the nuclear pore complex (NPC), required for assembly of the subcomplex and also for formation of the nucleocytoplasmic Gsp1p concentration gradient that plays a role in nuclear trafficking
Localization:
Intensity:
Fold change:
Significance:
-
C’ GFP library in SD
nuclear periphery40.77 -
N' NOP1pr-GFP in SD

N/A0 -
N' TEF2pr-mCherry in SD

N/A0 -
N' NATIVEpr-GFP in SD

N/A0 -
N' TEF2pr-VC and Cyto-VN in SD

N/A0 -
C’ GFP library in SD+DTT

nuclear periphery34.210.83No -
C’ GFP library in SD+H2O2

nuclear periphery39.910.97No -
C’ GFP library in Starvation Media
nuclear periphery41.451.01No -
C’ GFP library on the background of Pup2-DaMP

N/A -
C’ GFP library on the background of CCT mutant

N/A0N/AYes
